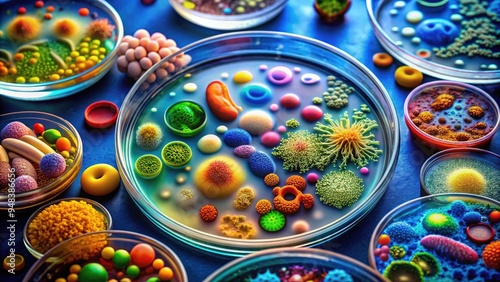

Download sample
File Details
Published: 2024-08-29 16:47:17.315227 Category: Food Type: Illustration Model release: NoShare
Colorful microscopic image of various microbial life forms, including bacteria, protozoa, and fungi, thriving in a petri dish or laboratory culture medium.
Contributor: Man888
ID : 948386656
